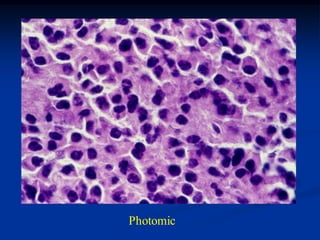
Photomic

This document discusses various types of round cell tumors of bone, including Ewing's sarcoma, large cell lymphoma, Hodgkin's lymphoma, leukemia, solitary plasmacytoma, and multiple myeloma. It provides details on the characteristics, presentation, diagnosis and treatment of each tumor type, with a focus on Ewing's sarcoma cases.